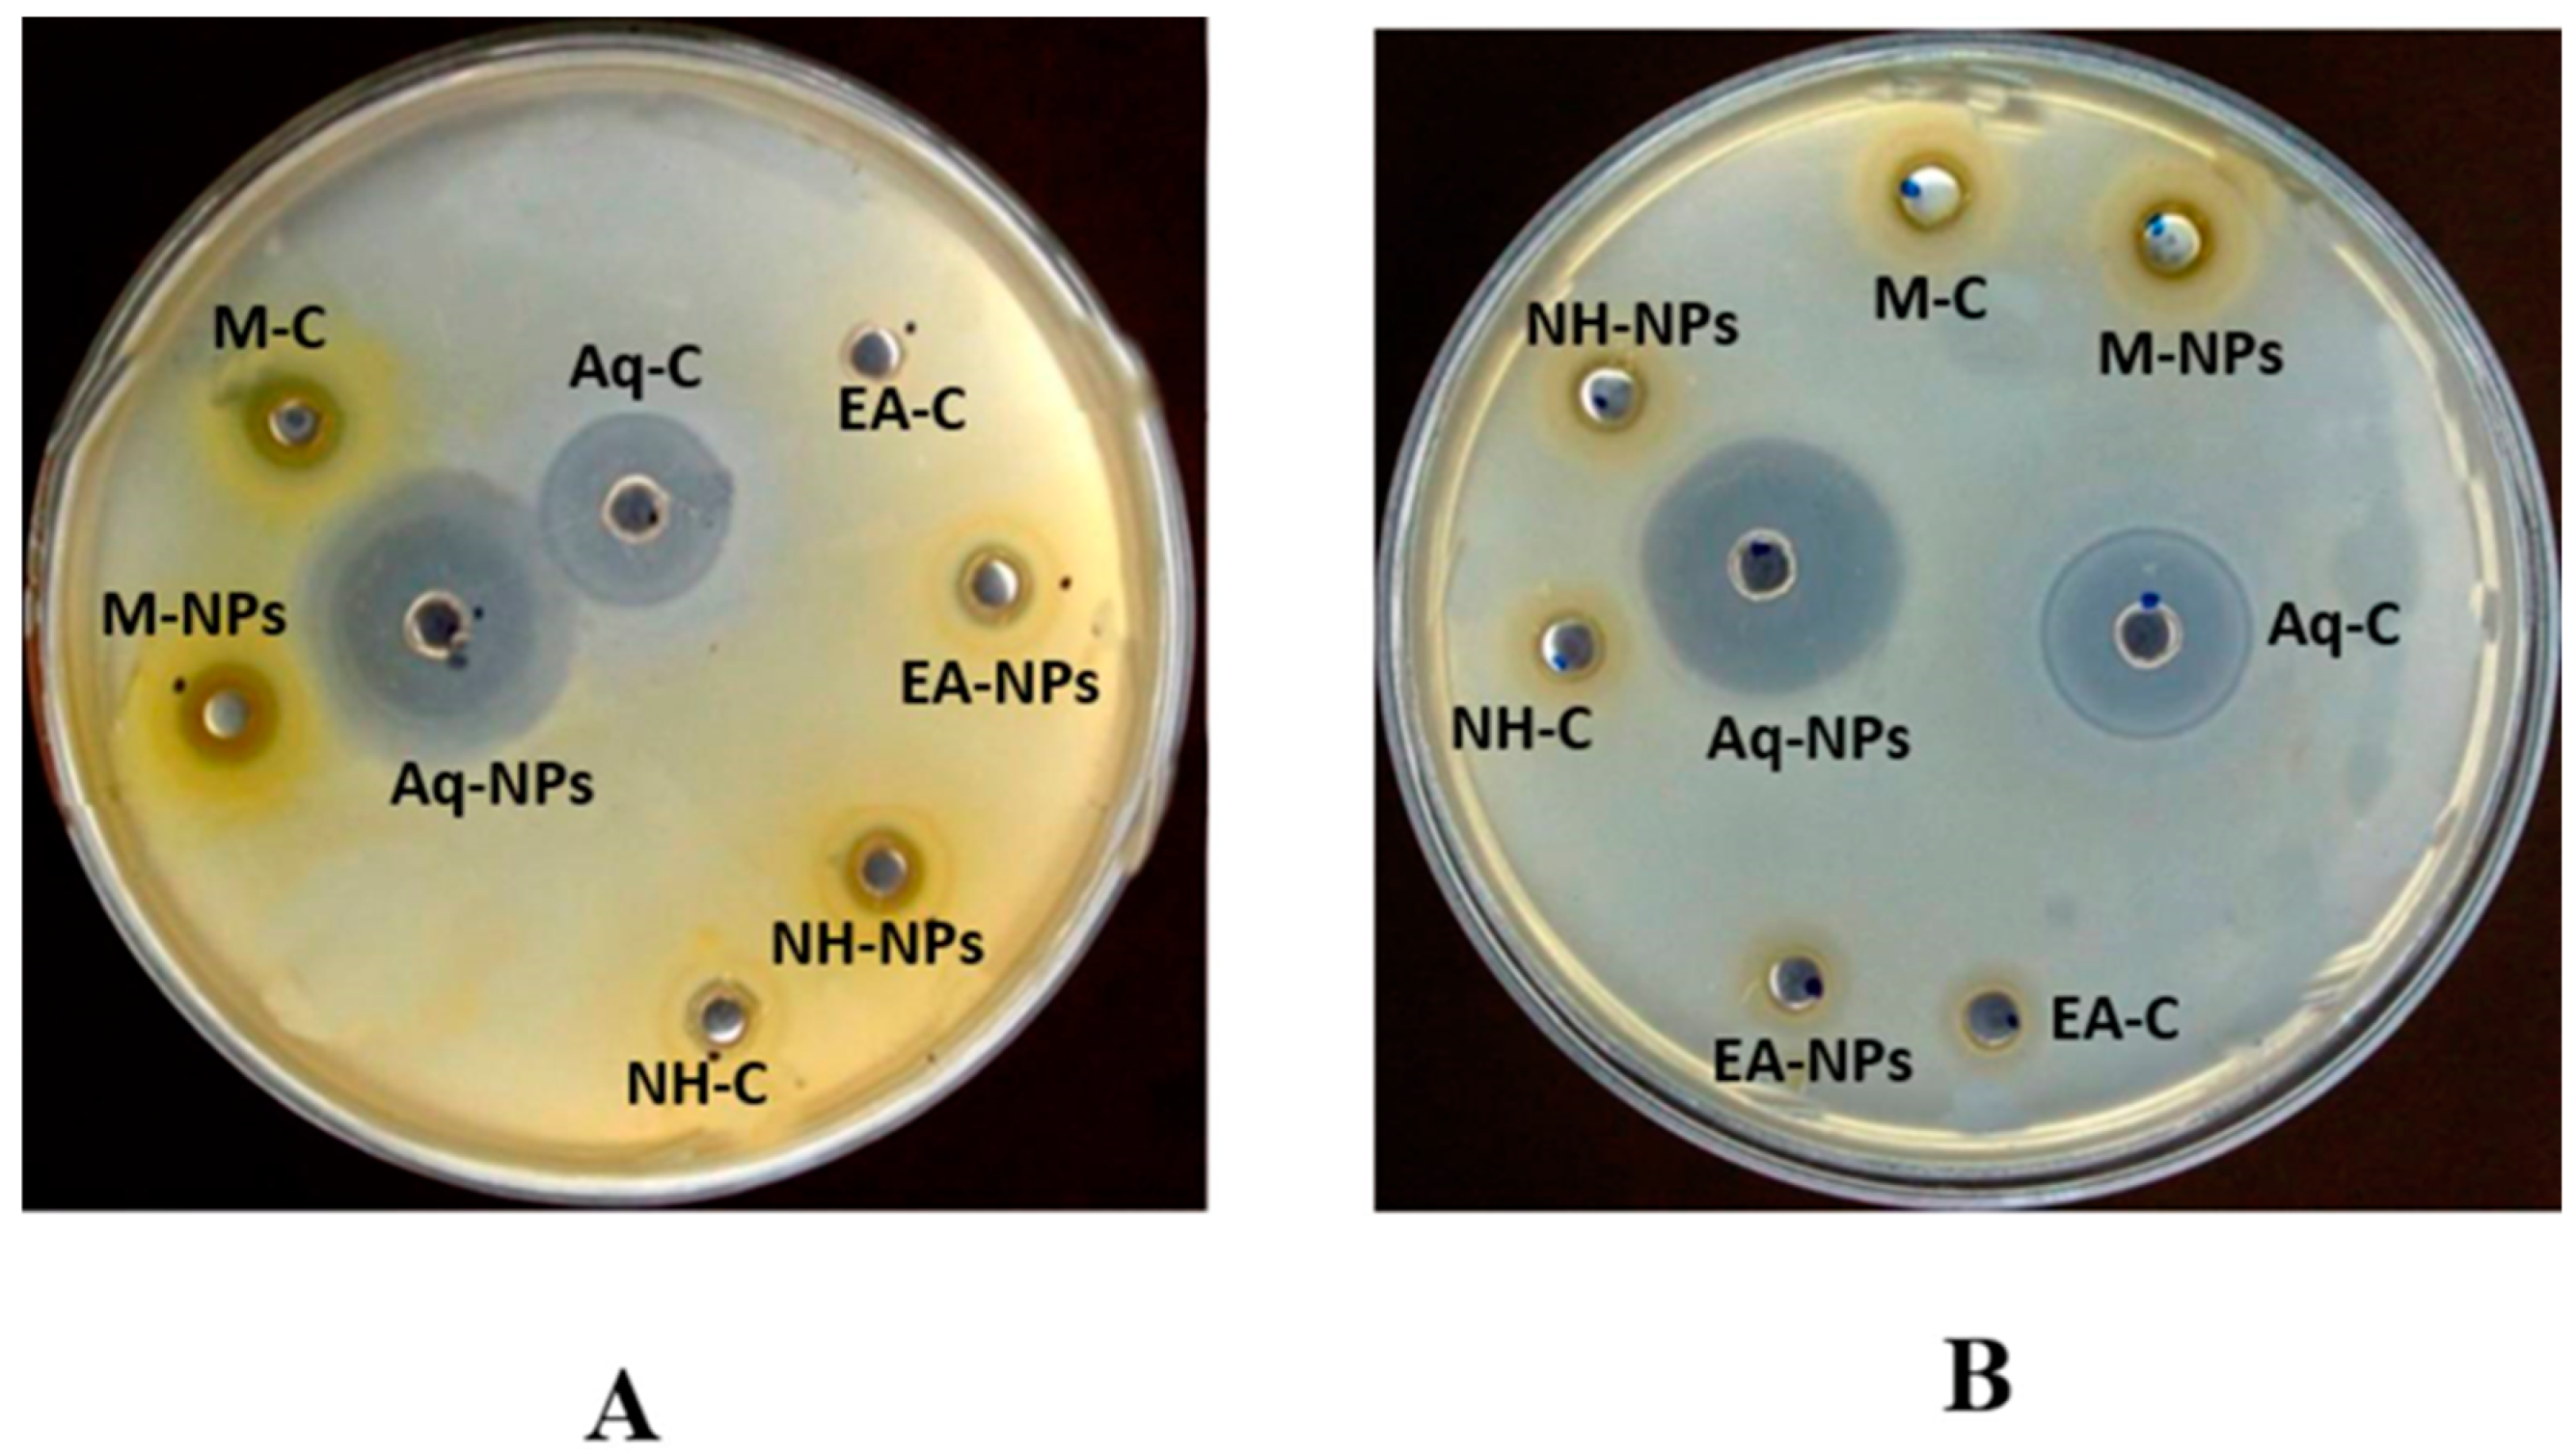
Plants 12 00362 g011 Plants 12 00362 g011

Biogenic Synthesis of Zinc Oxide Nanoparticles Using Citrullus colocynthis for Potential Biomedical Applications
Abstract
1. Introduction
2. Results
2.1. Extract Recovery
2.2. Synthesis of Zinc Oxide Nanoparticles
2.3. Characterization of Zinc Nanoparticles
2.4. Phytochemical Analysis
2.4.1. Total Phenolic Contents
2.4.2. Total Flavonoid Contents
2.4.3. Total Alkaloid Contents
2.5. Biological Activities
2.5.1. Antioxidant Assay
2.5.2. Antibacterial Assay
2.5.3. Antifungal Assay
2.5.4. Cytotoxicity Assay
2.6. Enzyme Inhibition Assays
2.6.1. Protein Kinase
2.6.2. Alpha-Amylase Assay
3. Discussion
4. Material and Methods
4.1. Collection of Plant Samples
4.2. Plant Extract Formulation
4.3. Synthesis of Zinc Oxide Nanoparticles (ZnONPs)
4.4. Characterization of Zinc Oxide Nanoparticles
4.4.1. UV–Visible Spectroscopy
4.4.2. Scanning Electron Microscopy Analysis (SEM)
4.4.3. X-ray Diffraction Analysis (XRD)
4.5. Phytochemical Analysis
4.5.1. Total Flavonoid Content Determination
4.5.2. Total Phenolic Content Determination
4.5.3. Total Alkaloids Determination
4.6. Biological Activities
4.6.1. Antibacterial Assay
4.6.2. Antifungal Assay
4.6.3. Brine Shrimp Cytotoxicity Assay
4.6.4. Free Radical Scavenging Activity
4.7. Enzyme Inhibition Assays
4.7.1. Protein Kinase Assay
4.7.2. α-Amylase Inhibition Assay
4.8. Statistical Analysis
5. Conclusions
Author Contributions
Funding
Institutional Review Board Statement
Informed Consent Statement
Data Availability Statement
Conflicts of Interest
References
- Selim, Y.A.; Azb, M.A.; Ragab, I.; Abd El-Azim, M.H.M. Green Synthesis of Zinc Oxide Nanoparticles Using Aqueous Extract of Deverra tortuosa and their Cytotoxic Activities. Sci. Rep. 2020, 10, 3445. [Google Scholar] [CrossRef] [PubMed]
- Li, Y.; Chen, S.M.; Ali, M.A.; Al-Hemaid, B. Biosynthesis and electrochemical characterization of silver nanoparticles from leaf extract of (Adenium obesum) and its application to antibacterial effect. Int. J. Electrochem. Sci. 2013, 8, 2691–2701. [Google Scholar]
- Geonmonond, R.; da Silva, A.; Camargo, P.H.C. Controlled synthesis of noble metal nanomaterials: Motivation, principles, and opportunities in nanocatalysis. An. Acad. Bras. Ciênc. 2018, 90, 719–744. [Google Scholar] [CrossRef] [PubMed]
- Hemanth, K.N.; Andia, J.D.; Manjunatha, S.; Murali, M.; Amruthesh, K.N.; Jagannath, S. Antimitotic and DNA-binding potential of biosynthesized ZnO-NPs from leaf extract of Justicia wynaadensis (Nees) Heyne—A medicinal herb. Biocatal. Agric. Biotechnol. 2019, 1, 101024. [Google Scholar] [CrossRef]
- Murali, M.; Mahendra, C.; Nagabhushan; Rajashekar, N.; Sudarshana, M.; Raveesha, K.; Amruthesh, K. Antibacterial and antioxidant properties of biosynthesized zinc oxide nanoparticles from Ceropegia candelabrum L.—An endemic species. Spectrochim. Acta A Mol. Biomol. Spectrosc. 2017, 179, 104–109. [Google Scholar] [CrossRef]
- Somu, P.; Paul, S. Protein assisted one pot controlled synthesis of monodispersed and multifunctional colloidal silver-gold alloy nanoparticles. J. Mol. Liq. 2019, 291, 111303. [Google Scholar] [CrossRef]
- Simon, S.; Sibuyi, N.R.S.; Fadaka, A.O.; Meyer, S.; Josephs, J.; Onani, M.O.; Meyer, M.; Madiehe, A.M. Biomedical Applications of Plant Extract-Synthesized Silver Nanoparticles. Biomedicines 2022, 10, 2792. [Google Scholar] [CrossRef]
- Rahuman, H.B.H.; Dhandapani, R.; Narayanan, S.; Palanivel, V.; Paramasivam, R.; Subbarayalu, R.; Thangavelu, S.; Muthupandian, S. Medicinal plants mediated the green synthesis of silver nanoparticles and their biomedical applications. IET Nanobiotechnol. 2022, 16, 115–144. [Google Scholar] [CrossRef]
- Anandan, S.; Mahadevamurthy, M.; Ansari, M.A.; Alzohairy, M.A.; Alomary, M.N.; Farha, S.S.; Sarjan, H.N.; Mahendra, C.; Lakshmeesha, T.R.; Hemanth, K.N.K. Biosynthesized ZnO-NPs from Morus indica attenuates methylglyoxal-induced protein glycation and RBC damage: In-vitro, in-vivo, and molecular docking study. Biomolecules 2019, 9, 882. [Google Scholar] [CrossRef]
- Kumar, N.K.H.; Murali, M.; Satish, A.; Singh, S.B.; Gowtham, H.G.; Mahesh, H.M.; Lakshmeesha, T.R.; Amruthesh, K.N.; Jagannath, S. Bioactive and Biocompatible Nature of Green Synthesized Zinc Oxide Nanoparticles from Simarouba glauca DC.: An Endemic Plant to Western Ghats, India. J. Clust. Sci. 2020, 31, 523–534. [Google Scholar] [CrossRef]
- Thatoi, P.; Kerry, R.G.; Gouda, S.; Das, G.; Pramanik, K.; Thatoi, H.; Patra, J.K. Photo-mediated green synthesis of silver and zinc oxide nanoparticles using aqueous extracts of two mangrove plant species, Heritiera fomes and Sonneratia apetala and investigation of their biomedical applications. J. Photochem. Photobiol. B Biol. 2016, 163, 311–318. [Google Scholar] [CrossRef]
- Ansari, M.A.; Murali, M.; Prasad, D.; Alzohairy, M.A.; Almatroudi, A.; Alomary, M.N.; Udayashankar, A.C.; Singh, S.B.; Asiri, S.M.M.; Ashwini, B.S.; et al. Cinnamomum verum Bark Extract Mediated Green Synthesis of ZnO Nanoparticles and Their Antibacterial Potentiality. Biomolecules 2020, 10, 336. [Google Scholar] [CrossRef] [PubMed]
- Prasad, K.S.; Prasad, S.K.; Ansari, M.A.; Alzohairy, M.A.; Alomary, M.N.; Alyahya, S.; Srinivasa, C.; Murali, M.; Ankegowda, V.M.; Shivamallu, C. Tumoricidal and Bactericidal Properties of ZnONPs Synthesized Using Cassia auriculata Leaf Extract. Biomolecules 2020, 10, 982. [Google Scholar] [CrossRef] [PubMed]
- Chunchegowda, U.A.; Shivaram, A.B.; Mahadevamurthy, M.; Ramachndrappa, L.T.; Lalitha, S.G.; Krishnappa, H.K.N.; Anandan, S.; Sudarshana, B.S.; Chanappa, E.G.; Ramachandrappa, N.S. Biosynthesis of Zinc Oxide Nanoparticles Using Leaf Extract of Passiflora subpeltata: Characterization and Antibacterial Activity Against Escherichia coli Isolated from Poultry Faeces. J. Clust. Sci. 2020, 32, 1663–1672. [Google Scholar] [CrossRef]
- Faisal, S.; Jan, H.; Shah, S.A.; Shah, S.; Khan, A.; Akbar, M.T.; Rizwan, M.; Jan, F.; Wajidullah; Akhtar, N.; et al. Green Synthesis of Zinc Oxide (ZnO) Nanoparticles Using Aqueous Fruit Extracts of Myristica fragrans: Their Characterizations and Biological and Environmental Applications. ACS Omega 2021, 6, 9709–9722. [Google Scholar] [CrossRef]
- Agarwal, H.; Shanmugam, V.K. Synthesis and optimization of zinc oxide nanoparticles using Kalanchoe pinnata towards the evaluation of its anti-inflammatory activity. J. Drug Deliv. Sci. Technol. 2019, 54, 101291. [Google Scholar] [CrossRef]
- Ali, S.G.; Ansari, M.A.; Jamal, Q.M.S.; Almatroudi, A.; Alzohairy, M.A.; Alomary, M.N.; Rehman, S.; Mahadevamurthy, M.; Jalal, M.; Khan, H.M.; et al. Butea monosperma seed extract mediated biosynthesis of ZnO NPs and their antibacterial, antibiofilm and anti-quorum sensing potentialities. Arab. J. Chem. 2021, 14, 103044. [Google Scholar] [CrossRef]
- Matinise, N.; Fuku, X.G.; Kaviyarasu, K.; Mayedwa, N.; Maaza, M. Applied Surface Science ZnO nanoparticles via Moringa oleifera green synthesis: Physical properties & mechanism of formation. Appl. Surf. Sci. 2017, 406, 339–347. [Google Scholar]
- Ahmed, S.; Ahmad, M.; Swami, B.L.; Ikram, S. A review on plants extract mediated synthesis of silver nanoparticles for antimicrobial applications: A green expertise. J. Adv. Res. 2015, 7, 17–28. [Google Scholar] [CrossRef]
- Ghorbanpour, M.M.; Mazloumi, M.; Nouri, A.; Lotfiman, A. Silver-doped Nano clay with antibacterial activity. J. Ultrafine Grained Nanostruct. Mater. 2017, 50, 124–131. [Google Scholar]
- Somu, P.; Paul, S. Casein based biogenic-synthesized zinc oxide nanoparticles simultaneously decontaminate heavy metals, dyes, and pathogenic microbes: A rational strategy for wastewater treatment. J. Chem. Technol. Biotechnol. 2018, 93, 2962–2976. [Google Scholar] [CrossRef]
- Albayaty, N. The most medicinal plants used in Iraq. Traditional knowledge. In Advances in Environmental Biology; American-Eurasian Network for Scientific Information: Amman, Jordan, 2011; pp. 401–406. [Google Scholar]
- Bourhia, M.; Bouothmany, K.; Bakrim, H.; Hadrach, S.; Salamatullah, A.M.; Alzahrani, A.; Khalil, A.H.; Albadr, N.A.; Gmouh, S.; Laglaoui, A.; et al. Chemical Profiling, Antioxidant, Antiproliferative, and Antibacterial Potentials of Chemically Characterized Extract of Citrullus colocynthis L. Seeds. Separations 2021, 8, 114. [Google Scholar] [CrossRef]
- Khare, C.P. Indian Medicinal Planta—An Illustrated Dictionary; Springer: New Delhi, India, 2007; pp. 717–718. [Google Scholar]
- Marzouk, B.; Marzouk, Z.; Fenina, N.; Bouraoui, A.; Aouni, M. Anti-inflammatory and analgesic activities of Tunisian Citrullus colocynthis Schrad. immature fruit and seed organic extracts. Eur. Rev. Med. Pharmacol. Sci. 2011, 15, 665–672. [Google Scholar] [PubMed]
- Murali, M.; Anandan, S.; Ansari, M.; Alzohairy, M.; Alomary, M.; Asiri, S.; Almatroudi, A.; Thriveni, M.; Singh, S.; Gowtham, H.; et al. Genotoxic and Cytotoxic Properties of Zinc Oxide Nanoparticles Phyto-Fabricated from the Obscure Morning Glory Plant Ipomoea obscura (L.) Ker Gawl. Molecules 2021, 26, 891. [Google Scholar] [CrossRef]
- Ahmed, S.; Saifullah; Ahmad, M.; Swami, B.L.; Ikram, S. Green synthesis of silver nanoparticles using Azadirachta indica aqueous leaf extract. J. Radiat. Res. Appl. Sci. 2016, 9, 1–7. [Google Scholar] [CrossRef]
- Meybodi, M.S. A review on pharmacological activities of Citrullus colocynthis (L.) Schrad. Asian J. Res. Rep. Endocrinol. 2020, 25, 25–34. [Google Scholar]
- Tannin-Spitz, T.; Bergman, M.; Grossman, S. Cucurbitacin glucosides: Antioxidant and free-radical scavenging activities. Biochem. Biophys. Res. Commun. 2007, 364, 181–186. [Google Scholar] [CrossRef]
- Duangmano, S.; Dakeng, S.; Jiratchariyakul, W.; Suksamrarn, A.; Smith, D.R.; Patmasiriwat, P. Antiproliferative effects of cucurbitacin B in breast cancer cells down-regulation of the c-Myc/hTERT/telomerase pathway and obstruction of the cell cycle. Int. J. Mol. Sci. 2010, 11, 5323–5338. [Google Scholar] [CrossRef]
- Christensen, L.; Vivekanandhan, S.; Misra, M.; Mohanty, A.K. Biosynthesis of silver nanoparticles using murraya koenigii (curry leaf): An investigation on the effect of broth concentration in reduction mechanism and particle size. Adv. Mater. Lett. 2011, 2, 429–434. [Google Scholar] [CrossRef]
- Zak, A.K.; Majid, W.A.; Mahmoudian, M.; Darroudi, M.; Yousefi, R. Starch-stabilized synthesis of ZnO nanopowders at low temperature and optical properties study. Adv. Powder Technol. 2013, 24, 618–624. [Google Scholar] [CrossRef]
- Jiang, J.; Pi, J.; Cai, J. The Advancing of Zinc Oxide Nanoparticles for Biomedical Applications. Bioinorg. Chem. Appl. 2018, 2018, 1062562. [Google Scholar] [CrossRef]
- Sirelkhatim, A.; Mahmud, S.; Seeni, A.; Kaus, N.H.M.; Ann, L.C.; Bakhori, S.K.M.; Hasan, H.; Mohamad, D. Review on Zinc Oxide Nanoparticles: Antibacterial Activity and Toxicity Mechanism. Nano-Micro Lett. 2015, 7, 219–242. [Google Scholar] [CrossRef] [PubMed]
- Saraniyadevi, J.; Bhimba, V. In-vitro anticancer activity of silver nanoparticles synthesized using the extract of (Gelidiella) species. Int. J. Pharm. 2012, 4, 710–715. [Google Scholar]
- Mahendra, C.; Chandra, M.N.; Murali, M.; Abhilash, M.; Singh, S.B.; Satish, S.; Sudarshana, M. Phyto-fabricated ZnO nanoparticles from Canthium dicoccum (L.) for antimicrobial, anti-tuberculosis and antioxidant activity. Process Biochem. 2020, 89, 220–226. [Google Scholar] [CrossRef]
- Siddhuraju, P.; Becker, K. Antioxidant properties of various solvent extracts of total phenolic constituents from three die rent agro climatic origins of drumstick tree (Moringa oleifera Lam.) leaves. J. Agric. Food Chem. 2003, 51, 2144–2155. [Google Scholar] [CrossRef]
- Soobrattee, M.A.; Neergheen, V.S.; Luximon-Ramma, A.; Aruoma, O.I.; Bahorun, T. Phenolics as potential antioxidant therapeutic agents: Mechanism and actions. Mutat. Res./Fund. Mol. Mech. Mutagen. 2005, 579, 200–213. [Google Scholar] [CrossRef]
- Adebooye, O.C.; Vijayalakshmi, R.; Singh, V. Peroxidase activity, chlorophylls, and antioxidant profile of two leaf vegetables (Solanum nigrum L. and Amaranthus cruentus L.) under six pretreatment methods before cooking. Int. J. Food Sci. Technol. 2008, 43, 173–178. [Google Scholar] [CrossRef]
- Yen, G.C.; Chuang, D.Y. Antioxidant properties of water extracts from (Cassia tora L.) in relation to the degree of roasting. J. Agric. Food Chem. 2000, 48, 2760–2765. [Google Scholar] [CrossRef]
- Uddin, M.K.; Juraimi, A.S.; Ali, M.E.; Ismail, M.R. Evaluation of antioxidant properties and mineral composition of purslane (Portulaca oleracea L.) at die rent growth stages. Int. J. Mol. Sci. 2012, 13, 10257–10267. [Google Scholar] [CrossRef]
- Burri, S.C.M.; Ekholm, A.; Håkansson, Å.; Tornberg, E.; Rumpunen, K. Antioxidant capacity and major phenol compounds of horticultural plant materials not usually used. J. Funct. Foods 2017, 38, 119–127. [Google Scholar] [CrossRef]
- Panche, A.N.; Diwan, A.D.; Chandra, S.R. Flavonoids: An overview. J. Nutr. Sci. 2020, 5, e47. [Google Scholar] [CrossRef] [PubMed]
- Wang, L.; Weller, C.L. Recent advances in extraction of nutraceuticals from plants. Trends Food Sci. Technol. 2006, 17, 300–312. [Google Scholar] [CrossRef]
- Shrestha, P.M.; Dhillion, S.S. Diversity and Traditional Knowledge Concerning Wild Food Species in a Locally Managed Forest in Nepal. Agrofor. Syst. 2006, 66, 55–63. [Google Scholar] [CrossRef]
- Sharmila, G.; Muthukumaran, C.; Sandiya, K.; Santhiya, S.; Pradeep, R.S.; Kumar, N.M.; Suriyanarayanan, N.; Thirumarimurugan, M. Biosynthesis, characterization, and antibacterial activity of zinc oxide nanoparticles derived from Bauhinia tomentose leaf extract. J. Nanostruct. Chem. 2018, 8, 293–299. [Google Scholar] [CrossRef]
- Azizi, S.; Mohamad, R.; Mahdavi Shahri, M. Green Microwave-Assisted Combustion Synthesis of Zinc Oxide Nanoparticles with Citrullus colocynthis (L.) Schrad: Characterization and Biomedical Applications. Molecules 2017, 22, 301. [Google Scholar] [CrossRef]
- Siripireddy, B.; Mandal, B.K. Facile green synthesis of zinc oxide nanoparticles by Eucalyptus globulus and their photocatalytic and antioxidant activity. Adv. Powder Technol. 2017, 28, 785–797. [Google Scholar] [CrossRef]
- Alamdari, S.; Ghamsari, M.S.; Lee, C.; Han, W.; Park, H.-H.; Tafreshi, M.J.; Afarideh, H.; Ara, M.H.M. Preparation and Characterization of Zinc Oxide Nanoparticles Using Leaf Extract of Sambucus ebulus. Appl. Sci. 2020, 10, 3620. [Google Scholar] [CrossRef]
- Sadighara, A.; Parisa, S.; Moghadam, A.J.; Golamreza, J.; Nabi, S.; Akbar, A.L. Potential therapeutic effects of (Morus alba) leaf extract on modulation oxidative damages induced by hyperglycemia in cultured fetus fibroblast cells. Glob. Vet. 2013, 10, 456–467. [Google Scholar]
- Ghagane, S.C.; Puranik, S.I.; Kumbar, V.M.; Nerli, R.B.; Jalalpure, S.S.; Hiremath, M.B. In-vitro antioxidant and anticancer activity of (Lee indica) leaf extracts on human prostate cancer cell lines. Integr. Med. Res. 2017, 6, 79–87. [Google Scholar] [CrossRef]
- Fukumoto, L.R.; Mazza, G. Assessing Antioxidant and Prooxidant Activities of Phenolic Compounds. J. Agric. Food Chem. 2000, 48, 3597–3604. [Google Scholar] [CrossRef]
- Khan, Z.U.H.; Sadiq, H.M.; Shah, N.S.; Khan, A.U.; Muhammad, N.; Hassan, S.U.; Tahir, K.; Safi, S.Z.; Khan, F.U.; Imran, M.; et al. Greener synthesis of zinc oxide nanoparticles using Trianthema portulacastrum extract and evaluation of its photocatalytic and biological applications. J. Photochem. Photobiol. B Biol. 2019, 192, 147–157. [Google Scholar] [CrossRef] [PubMed]
- Mayerhof, E.R.; Koncz-Kalman, R.Z.; Nawrath, C.; Bakkeren, G.; Crameri, A.; Angelis, K.; Redei, G.P.; Schell, J.B.; Hohn, K.J. T-DNA integration a mode of illegitimate recombination inplants. EMBO J. 2009, 10, 697–704. [Google Scholar] [CrossRef] [PubMed]
- Bisht, G.; Rayamajhi, S. ZnO Nanoparticles: A Promising Anticancer Agent. Nanobiomedicine 2016, 3, 3–9. [Google Scholar] [CrossRef] [PubMed]
- Gunalana, S.; Sivaraja, R.; Rajendran, V. Green synthesized ZnO nanoparticles against bacterial and fungal pathogens. Prog. Nat. Sci. 2012, 22, 693–700. [Google Scholar] [CrossRef]
- Pal, S.; Tak, Y.K.; Song, J.M. Does the Antibacterial Activity of Silver Nanoparticles Depend on the Shape of the Nanoparticle? A Study of the Gram-Negative Bacterium Escherichia coli. Appl. Environ. Microbiol. 2007, 73, 1712–1720. [Google Scholar] [CrossRef]
- Santosh, V.; Thakkar, S.; Kevin, M.; Allegre, S.B.; Joshi, D.B.; Volkin, C.; Russell, M. An application of ultraviolet spectroscopy to study interactions in proteins solutions at high concentrations. Pharm. Sci. 2012, 101, 305. [Google Scholar]
- Schaffer, B.; Hohenester, U.; Trügler, A.; Hofer, F. High-resolution surface plasmon imaging of gold nanoparticles by energy-filtered transmission electron microscopy. Phys. Rev. B 2009, 79, 041401. [Google Scholar] [CrossRef]
- Ul-Haq, I.; Ullah, N.; Bibi, G.; Kanwal, S.; Ahmad, M.S.; Mirza, B. Antioxidant and Cytotoxic Activities and Phytochemical Analysis of Euphorbia wallichii Root Extract and its Fractions. Iran. J. Pharm. Res. 2012, 11, 241–249. [Google Scholar] [CrossRef]
- Ajanal, M.; Gundkalle, M.B.; Nayak, S.U. Estimation of total alkaloid in Chitrakadivati by UV-Spectrophotometer. Anc. Sci. Life 2012, 31, 198–201. [Google Scholar] [CrossRef]
- Zahra, S.S.; Ahmed, M.; Qasim, M.; Gul, B.; Zia, M.; Mirza, B. Polarity-based characterization of biologically active extracts of Ajuga bracteosa Wall ex. Benth and RP-HPLC analysis. BMC Complement. Altern. Med. 2017, 17, 443. [Google Scholar] [CrossRef]
- Kebede, T.; Gadisa, E.; Tufa, A. Antimicrobial activities evaluation and phytochemical screening of some selected medic-inal plants: A possible alternative in the treatment of multidrug-resistant microbes. PLoS ONE 2021, 16, e0249253. [Google Scholar] [CrossRef] [PubMed]
- Hameed, B.; Ali, Q.; Hafeez, M.M.; Malik, A. Antibacterial and antifungal activity of fruit, seed and root extracts of Citrullus colocynthis plant. Biol. Clin. Sci. Res. J. 2020, 2020. [Google Scholar] [CrossRef]
- Fatima, H.; Khan, K.; Zia, M.; Ur-Rehman, T.; Mirza, B.; Haq, I.-U. Extraction optimization of medicinally important metabolites from Datura innoxia Mill.: An in vitro biological and phytochemical investigation. BMC Complement. Altern. Med. 2015, 15, 376. [Google Scholar] [CrossRef] [PubMed]
- Kim, J.S.; Kwon, C.S.; Sou, K.H. Inhibition of alpha glycosidase and amylase luteolin a flavonoid. Biosci. Biotechnol. Biochem. 2000, 64, 2458–2461. [Google Scholar] [CrossRef]

| Extract Codes | Extract Recovery | |||
|---|---|---|---|---|
| Leaves | Fruit | |||
| Total Quantity | Divisions | Total Quantity | Divisions | |
| nH | 400 mL | 200/200 mL | 400 ml | 200/200 mL |
| EA | 400 mL | 200/200 mL | 400 ml | 200/200 mL |
| M | 450 mL | 225/225 mL | 450 ml | 225/225 mL |
| Aq | 450 mL | 225/225 mL | 450 ml | 225/225 mL |
| Extract Name | Sample | Diameter of Zone of Inhibition in mm (Mean SD) (MIC:µg/mL) | |||||||||
|---|---|---|---|---|---|---|---|---|---|---|---|
| P.A | MIC | K.P | MIC | S.A | MIC | E.C | MIC | B.S | MIC | ||
| Leaves | |||||||||||
| nH | C | 8 ± 0.40 | --- | 12 ± 0.36 | 100 | 6 ± 0.18 | --- | 12 ± 0.18 | 100 | 15 ± 0.27 | 100 |
| NP | 10 ± 0.25 | --- | 39 ± 0.43 * | 3.7 | 8 ± 0.25 | --- | 18 ± 0.25 * | 100 | 28 ± 0.41 * | 33.3 | |
| EA | C | 6 ± 0.28 | --- | 12 ± 0.25 | 100 | 10 ± 0.3 | --- | 13 ± 0.27 | 100 | 12 ± 0.19 | 100 |
| NP | 7 ± 0.28 | --- | 28 ± 0.19 * | 3.7 | 7 ± 0.19 | --- | 24 ± 0.19 * | 33.3 | 18 ± 0.28 * | 100 | |
| M | C | 11 ± 0.25 | --- | 15 ± 0.41 | 100 | 11 ± 0.6 | --- | 13 ± 0.27 | 100 | 12 ± 0.17 | 100 |
| NP | 13 ± 0.27 | 100 | 21 ± 0.48 * | 100 | 12 ± 0.17 | 100 | 17 ± 0.65 * | 100 | 14 ± 0.23 | 100 | |
| Aq | C | 8 ± 0.12 | --- | 13 ± 0.40 | 100 | 6 ± 0.45 | --- | 28 ± 0.27 | 11.1 | 21 ± 0.45 | 33.3 |
| NP | 7 ± 0.21 | --- | 24 ± 0.32 * | 33.3 | 12 ± 0.2 * | --- | 39 ± 0.43 * | 3.7 | 34 ± 0.19 * | 3.7 | |
| Fruits | |||||||||||
| nH | C | 6 ± 0.12 | --- | 15 ± 0.56 | 100 | 4 ± 0.2 | --- | 12 ± 0.12 | 100 | 8 ± 0.12 | --- |
| NP | 7 ± 0.25 | --- | 21 ± 0.19 * | 33.3 | 6 ± 0.10 | --- | 21 ± 0.17 * | 33.3 | 11 ± 0.12 * | --- | |
| EA | C | 5 ± 0.18 | --- | 12 ± 0.32 | 100 | 8 ± 0.25 | --- | 13 ± 0.27 | 100 | 6 ± 0.7 | --- |
| NP | 5 ± 0.18 | --- | 18 ± 0.25 * | 100 | 8 ± 0.25 | --- | 17 ± 0.65* | 100 | 8 ± 0.6 | --- | |
| M | C | 8 ± 0.35 | --- | 12 ± 0.30 | 100 | 6 ± 0.32 | --- | 12 ± 0.21 | 100 | 12 ± 0.51 | 100 |
| NP | 12 ± 0.2 * | 100 | 13 ± 0.18 | 100 | 8 ± 0.35 | --- | 25 ± 0.6 * | 33.3 | 21 ± 0.32 * | 33.3 | |
| Aq | C | 9 ± 0.41 | --- | 16 ± 0.21 | 100 | 5 ± 0.62 | --- | 12 ± 0.12 | 100 | 15 ± 0.25 | 100 |
| NP | 13 ± 0.2 * | 100 | 17 ± 0.21 | 100 | 5 ± 0.62 | --- | 14 ± 0.8 | 100 | 25 ± 0.21 * | 33.3 | |
| Controls | |||||||||||
| Cef. | 22 ± 0.88 | 1.11 | 20 ± 0.12 | 1.11 | *** | *** | 20 ± 1.5 | 3.33 | *** | *** | |
| Rox. | *** | *** | *** | *** | 23 ± 0.54 | 1.11 | *** | *** | 23 ± 0.54 | 1.11 | |
| DMSO | ---- | ---- | --- | --- | --- | --- | --- | --- | --- | --- | |
| Plant Part | Extracts | Samples | Antifungal Activity | |||
|---|---|---|---|---|---|---|
| Zone of Inhibition (mm) | ||||||
| A. flavus | A. fumigatus | Mucor sp. | F. solani | |||
| Leaves | n-Hexane | NP | --- | --- | --- | --- |
| C | --- | --- | --- | 7 ± 0.02 | ||
| Ethyl acetate | NP | --- | --- | --- | 7 ± 0.02 * | |
| C | --- | --- | --- | --- | ||
| Methanol | NP | --- | 7 ± 0.03 * | --- | 12 ± 0.01 | |
| C | --- | --- | --- | 9 ± 0.04 | ||
| Aqueous | NP | 7 ± 0.01 * | --- | --- | 11 ± 0.02 | |
| C | --- | --- | --- | 10 ± 0.01 | ||
| Fruits | n-Hexane | NP | --- | 11 ± 0.01 | --- | 11 ± 0.03 |
| C | --- | 10 ± 0.02 | --- | 13 ± 0.02 | ||
| Ethyl acetate | NP | --- | 11 ± 0.06 | --- | 12 ± 0.01 | |
| C | --- | 10 ± 0.02 | --- | 12 ± 0.01 | ||
| Methanol | NP | 7 ± 0.02 * | 13 ± 0.01 | --- | 11 ± 0.02 | |
| C | --- | 12 ± 0.05 | --- | 13 ± 0.01 | ||
| Aqueous | NP | --- | 12 ± 0.12 | --- | 13 ± 0.08 | |
| C | --- | 11 ± 0.09 | --- | 11 ± 0.09 | ||
| Positive Controls | Clotrim. | 20 ± 0.01 | 24 ± 0.03 | 27 ± 0.02 | 28 ± 0.01 | |
| DMSO | --- | --- | --- | --- | ||
| Plant Parts | Extracts | Samples | Percent Mortality ± STD (Conc. in µg/mL) | |||
|---|---|---|---|---|---|---|
| 200 | 100 | 50 | LC50 | |||
| CC leaves | n-Hexane | NP | 50 ± 1.50 * | 60 ± 1.00 * | 60 ± 1.00 | 46.84 |
| C | 100 ± 1.50 | 100 ± 1.50 | 60 ± 1.40 | 42.41 | ||
| Ethyl acetate | NP | 60 ± 1.50 | 40 ± 1.00 * | 10 ± 1.50 * | 110.45 | |
| C | 80 ± 1.50 | 80 ± 1.50 | 60 ± 1.70 | 72.92 | ||
| Methanol | NP | 60 ±1.25 | 10 ± 1.60 | 10 ± 1.40 | 150.6 | |
| C | 40 ± 0.85 | 20 ± 0.25 | --- | >200 | ||
| Aqueous | NP | 20 ± 1.5 | 20 ± 1.50 | --- | >200 | |
| C | 20 ± 1.75 | 10 ± 1.50 | --- | >200 | ||
| CC fruit | n-Hexane | NP | 40 ± 1.50 * | 40 ± 1.50 | 10 ± 1.40 | 130.5 |
| C | 70 ± 1.5 | 30 ± 1.0 | 10 ± 1.30 | 140.6 | ||
| Ethyl acetate | NP | 10 ± 1.50 * | 10 ± 1.00 | 60 ± 1.00 | 146 | |
| C | 60 ± 1.2 | 20 ± 1.5 | 10 ± 1.60 | 170.6 | ||
| Methanol | NP | 70 ± 1.00 | 30 ± 1.50 * | 10 ± 1.70 * | 185.8 | |
| C | 70 ± 1.15 | 60 ± 1.25 | 40 ± 1.00 | >200 | ||
| Aqueous | NP | --- | --- | --- | --- | |
| C | 30 ± 1.50 | 10 ± 1.00 | --- | >200 | ||
| Plant Parts | Extracts | Samples | Numerical Value | Activity |
|---|---|---|---|---|
| Leaves | n-Hexane | NP | 11 | Clear |
| C | 5 | NA | ||
| Ethyl acetate | NP | 78 | Clear | |
| C | 12 | Clear | ||
| Methanol | NP | 28 | Clear\Bald | |
| C | 17 | Bald | ||
| Aqueous | NP | 10 | Clear | |
| C | 35 | Clear | ||
| Fruits | n-Hexane | NP | 49 | Bald |
| C | 5 | NA | ||
| Ethyl acetate | NP | 28 | Clear | |
| C | 5 | NA | ||
| Methanol | NP | 48 | Clear | |
| C | 64 | Bald | ||
| Aqueous | NP | 19 | Bald | |
| C | 15 | Clear |
Disclaimer/Publisher’s Note: The statements, opinions and data contained in all publications are solely those of the individual author(s) and contributor(s) and not of MDPI and/or the editor(s). MDPI and/or the editor(s) disclaim responsibility for any injury to people or property resulting from any ideas, methods, instructions or products referred to in the content. |
© 2023 by the authors. Licensee MDPI, Basel, Switzerland. This article is an open access article distributed under the terms and conditions of the Creative Commons Attribution (CC BY) license (https://creativecommons.org/licenses/by/4.0/).
Share and Cite
Kiani, B.H.; Ajmal, Q.; Akhtar, N.; Haq, I.-u.; Abdel-Maksoud, M.A.; Malik, A.; Aufy, M.; Ullah, N. Biogenic Synthesis of Zinc Oxide Nanoparticles Using Citrullus colocynthis for Potential Biomedical Applications. Plants 2023, 12, 362. https://doi.org/10.3390/plants12020362
Kiani BH, Ajmal Q, Akhtar N, Haq I-u, Abdel-Maksoud MA, Malik A, Aufy M, Ullah N. Biogenic Synthesis of Zinc Oxide Nanoparticles Using Citrullus colocynthis for Potential Biomedical Applications. Plants. 2023; 12(2):362. https://doi.org/10.3390/plants12020362
Chicago/Turabian StyleKiani, Bushra Hafeez, Qudsia Ajmal, Nosheen Akhtar, Ihsan-ul Haq, Mostafa A. Abdel-Maksoud, Abdul Malik, Mohammed Aufy, and Nazif Ullah. 2023. "Biogenic Synthesis of Zinc Oxide Nanoparticles Using Citrullus colocynthis for Potential Biomedical Applications" Plants 12, no. 2: 362. https://doi.org/10.3390/plants12020362
APA StyleKiani, B. H., Ajmal, Q., Akhtar, N., Haq, I.-u., Abdel-Maksoud, M. A., Malik, A., Aufy, M., & Ullah, N. (2023). Biogenic Synthesis of Zinc Oxide Nanoparticles Using Citrullus colocynthis for Potential Biomedical Applications. Plants, 12(2), 362. https://doi.org/10.3390/plants12020362

